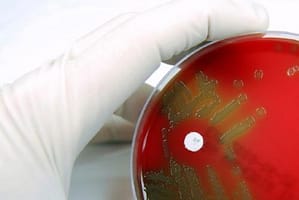

Infección del Tracto Urinario en Hombres. Presentación del Problema
Si bien las cistitis y las pielonefritis son diagnósticos comunes en hombres y mujeres, varias formas de IU están asociadas a factores de riesgo exclusivos de los hombres como las obstrucciones urinarias de origen prostática, o a procedimientos cistourológicos de frecuente utilización en la evaluación de síntomas obstructivos urinarios.
Fuente: Consenso Argentino Intersociedades para el Manejo de la Infección del Tracto Urinario – Parte II Intersociety Argentinean Consensus for Management of the Urinary Tract Infection -Part II
Sociedades Participantes:Sociedad Argentina de Infectología (SADI),Sociedad Argentina de Urología (SAU),Sociedad Argentina de Medicina (SAM),Sociedad Argentina de Bacteriología Clínica (SADEBAC), Sociedad de Ginecología y Obstetricia de Buenos Aires (SOGIBA)
Autores del Consenso: Coordinador: Gabriel Levy Hara1 (SADI), Secretario: Gustavo Lopardo2 (SADI)
Participantes:SADI: María José López Furst3, Liliana Clara4, Daniel Pryluka5, Javier Desse6, Liliana Vázquez7, Gabriela Saravia8, Joaquín Bermejo9, Jorge Gentile10, Sergio Prieto11, Beatriz Ricci12 y Alicia Lizzi13. SAU: Daniel Varcasia14, José Simhan15, Luis Lisenfeld16 y Daniel Ekizian17,SADEBAC: Horacio Lopardo18, Jorgelina Smayevsky19, Federico Nicola20 y Sara Kaufman21.SAM: Manuel Klein22, Claudio Baldomir23 y Gustavo Badariotti24.SOGIBA: Francisco Basilio25, Juan Carlos Nassif26 y César Ponce27.
1 Infectólogo, Servicio de Infectología, Hospital Durand, Buenos Aires, Argentina.2 Infectólogo, Servicio de Infectología, Hospital Bernardo Houssay, Vicente López (Pcia. de Buenos Aires), Argentina.3 Infectóloga, Servicio de Infectología, Sanatorio Méndez, Buenos Aires, Argentina.4 Infectóloga, Servicio de Infectología, Hospital Italiano, Buenos Aires, Argentina.5 Infectólogo, Servicio de Infectología, Hospital Vélez Sársfield,Buenos Aires, Argentina.6 Infectólogo, Servicio de Infectología, Hospital HIGA Diego Paroissien, Isidro Casanova (Pcia. de Buenos Aires), Argentina.7 Infectóloga, Fundación Centro de Estudios Infectológicos,Buenos Aires, Argentina.8 Médica Clínica, Hospital Italiano, Buenos Aires, Argentina.9 Infectólogo, Unidad de Enfermedades Infecciosas, Hospital Español, Rosario (Pcia. de Santa Fe), Argentina.10 Infectólogo, Servicio de Infectología, Hospital Ramón Santamarina, Tandil (Pcia. de Buenos Aires), Argentina.11 Infectólogo, Servicio de Infectología, Hospital Carlos Bocalandro, LomaHermosa (Pcia. de Buenos Aires), Argentina.12 Infectóloga, Servicio de Infectología, Instituto de Rehabilitación Psicofísica, Buenos Aires, Argentina.13 Enfermera en Control de Infecciones, Servicio de Infectología, Hospital Italiano, Buenos Aires, Argentina.14 Urólogo, Unidad de Urología, Hospital Aeronáutico Central, Buenos Aires, Argentina.15 Urólogo, Unidad de Urología, Hospital Aeronáutico Central, Buenos Aires, Argentina.16 Urólogo, Unidad de Urología, Hospital Aeronáutico Central, Buenos Aires, Argentina.17 Urólogo, Unidad de Urología, Hospital Israelita, Buenos Aires, Argentina.18 Microbiólogo, Servicio de Microbiología, Hospital de Pediatría “Prof. Dr. Juan P. Garrahan”, Buenos Aires, Argentina.19 Bioquímica, Especialista en Microbiología Clínica, Laboratorio de Microbiología, CEMIC, Buenos Aires, Argentina.20 Microbiólogo, Laboratorios Britania, Buenos Aires, Argentina.
Correspondencia:Dr. Gabriel Levy Hara.Av. Díaz Vélez 5044, 1406 Buenos Aires,Argentina.e-mail: glevyhara@fibertel.com.ar
Las infecciones urinarias (IU) en hombres jóvenes no son frecuentes y siempre se consideran complicadas (1). Son infecciones cuya incidencia es poco significativa hasta alrededor de los 50 años. A partir de esta edad, el agrandamiento prostático, las prostatitis y las instrumentaciones de la vía urinaria aparecen como las causas relacionadas con el aumento de incidencia de IU en el hombre.
El estudio “Urologic Disease in America Project” informa que aproximadamente el 20% de todas las IU se presentan en hombres. Entre los años 1988 y 1994 la prevalencia estimada de IU en hombres fue de 13.7/100.000 (2). Un estudio en hombres jóvenes informó de una incidencia de 5 infecciones urinarias cada 10.000 personas por año (3).
La diferencia significativa en los índices de IU entre ambos sexos de edades similares se debería a diferencias anatómicas. Entre otros factores la longitud de la uretra, el entorno “seco” del meato uretral en el hombre y las propiedades antibacterianas del fluido prostático podrían explicar los menores índices de IU en el hombre (4).
Factores de Riesgo
Si bien las cistitis y las pielonefritis son diagnósticos comunes en hombres y mujeres, varias formas de IU están asociadas a factores de riesgo exclusivos de los hombres como las obstrucciones urinarias de origen prostática, o a procedimientos cistourológicos de frecuente utilización en la evaluación de síntomas obstructivos urinarios.
Historia sexual
En relación con la historia sexual, debe tenerse en cuenta que:
a) Las bacterias productoras de IU en el hombre suelen correlacionar con las encontradas en la flora vaginal de la pareja (5).
b) El antecedente de uretritis puede justificar la presencia de estructuras uretrales responsables de síntomas irritativos u obstructivos, pudiendo generar residuos posmiccionales.
c) La mayor práctica del sexo anal insertivo incrementa los riesgos de IU. En este punto debe distinguirse lo que se denomina hábitos sexuales de la orientación sexual. De este modo, la exposición a enterobacterias, independientemente del mecanismo, constituye un importante factor de riesgo. Por su parte, también predisponen a IU en el hombre las prácticas de inserción de objetos en la uretra (6).
La circuncisión
Desde hace más de 2 décadas se estableció que los pacientes no circuncidados presentaban mayor riesgo de IU. Más recientemente se halló que pacientes varones jóvenes incircuncisos presentaron mayores porcentajes de bacteriuria que los circuncidados, efectos que persistirían en los adultos jóvenes. Estas observaciones se extendieron a la infección por VIH, que se relacionó con una mayor frecuencia de úlceras genitales como puerta de entrada para otros patógenos de transmisión sexual (7).
IU en hombres con infección por VIH/SIDA
En un estudio llevado a cabo incluyendo pacientes masculinos con y sin diagnóstico de SIDA y portadores del VIH asintomáticos, se halló incrementada la frecuencia de bacteriuria asintomática y de IU sintomática en el grupo de pacientes con SIDA (8).
La Toma de Muestra
Se recomienda instruir al hombre en la higienización el meato uretral con agua y jabón y obtener la muestra de orina del chorro medio de una micción retrayendo el prepucio. Esto puede ser dificultoso en ancianos, en quienes las muestras pueden contaminarse.
En pacientes con incontinencia se recomienda obtener orina mediante la colocación transitoria de una sonda K30, del mismo modo que fue referido en otros apartados de este Consenso (ver Infecciones urinarias en mujeres institucionalizadas).
Criterios de Bacteriuria en Hombres
Se debe considerar bacteriuria significativa a la presencia de >103 CFU/mL de una flora única y predominante (sensibilidad y especificidad de 0.97). La toma de una sola muestra es adecuada para el diagnóstico en el 95% de los casos (9,10).
Etiología
Al igual que en mujeres, los bacilos gram negativos son los gérmenes involucrados con mayor frecuencia.
La E. coli, que en las mujeres causa entre un 80% y un 90% de todas las IU, en los hombres es responsable de entre el 40 y el 50% de los episodios. El Proteus spp y la Providencia spp son más frecuentes en hombres que en las mujeres. Además, las IU en esta población pueden ser causadas por gram positivos como Enterococcus spp, Staphylococcus spp o estreptococos.
Tratamiento
Es notable la escasez de estudios controlados que evalúan el tratamiento de IU en hombres, hecho probablemente relacionado con la menor frecuencia de IU en esta población, comparada con la mujer adulta.
Se dispone de recomendaciones de tratamientos empíricos para cistitis y pielonefritis en hombres, que se han basado en las elaboradas para mujeres (6,11).
Se recomienda guiar el tratamiento acorde a los cultivos. Sólo si el caso clínico no admite retraso se deberá prescribir un tratamiento empírico. La selección del ATB para dicho tratamiento no difiere sustancialmente de otras situaciones desarrolladas en este Consenso. Según la sensibilidad local, los antecedentes particulares de cada paciente (uso de ATB, instrumentaciones, presencia de obstrucciones u otras anomalías anatómicas) se podrán utilizar TMS, fluoroquinolonas (como ciprofloxacina) o alguna de las alternativas señaladas en “Infecciones en pacientes con cálculos urinarios”.
Los pacientes con pielonefritis aguda responden de modo inconsistente a la nitrofurantoína, y pueden ocurrir bacteriemias intra-tratamiento con esta droga.
Por lo tanto, no se recomienda utilizar nitrofurantoína para el tratamiento de los pacientes con pielonefritis, insuficiencia renal o infección prostática.
En pacientes con sospecha de infección prostática se recomienda utilizar una fluoroquinolona, ya que esta clase de drogas alcanza niveles terapéuticos más elevados en dicho órgano (Ver Tabla) (6).
No se ha comprobado que los cursos cortos de antibióticos – de eficacia demostrada en mujeres – sean apropiados para el tratamiento de las IU en hombres.
Se recomienda que la extensión de los tratamientos en hombres no sea menor a 7 días, e inclusive tratamientos más prolongados pueden reducir la probabilidad de infecciones prostáticas persistentes (6). Un ensayo aleatorizado y controlado que utilizó ciprofloxacina 500 mg oral administrada dos veces al día durante 2 o 4 semanas en IU febril en hombres, que fueron seguidos durante un 1 año, mostró que 2 semanas constituyen un tiempo adecuado para el tratamiento de IU febril en hombres (12).
Por lo tanto, se sugiere mantener el tratamiento durante 7 a 10 días para las IU bajas, y entre 10 y 14 días para las pielonefritis.
Las bacteriurias asintomáticas no requieren tratamiento en el hombre.
Puntos prácticos
*No se ha comprobado que los cursos cortos de antibióticos ensayados con eficacia en mujeres sean apropiados en tratamientos en hombres.
*Según la sensibilidad local, los antecedentes particulares de cada paciente (uso de ATB, instrumentaciones, presencia de obstrucciones u otras anomalías anatómicas) se recomienda utilizar TMS, fluoroquinolonas (como ciprofloxacina) o alguna de las alternativas señaladas en “Infecciones en pacientes con cálculos urinarios”.
*No se recomienda utilizar nitrofurantoína para el tratamiento de los pacientes con pielonefritis, insuficiencia renal o infección prostática.
*Se sugiere mantener el tratamiento durante 7 a 10 días para las IU bajas, y entre 10 y 14 días para las pielonefritis.
Evaluaciones en Hombres con Infección Urinaria
Habitualmente el diagnóstico de IU en un hombre genera un alto grado de sospecha de algún problema estructural subyacente que requerirá evaluaciones adicionales (4,13). Sin embargo, no existe un consenso acerca de cómo y cuándo evaluar a estos pacientes, tanto a los más jóvenes como a aquéllos de mayor edad.
Existe un concepto muy difundido en el ámbito médico respecto de que es necesario evaluar en forma rutinaria a todos los hombres con IU, para pesquisar lesiones estructurales que condicionen su aparición.
Sin embargo, un estudio prospectivo (14) que incluyó 85 hombres (edad media 63 años, rango 18-86) con IU febril provenientes de la comunidad, a quienes se investigó la vía urinaria (urografía excretora, cistouretros-copía, uroflujometría, tacto rectal y estudio de residuo posmiccional) y seguidos durante un año, concluyó que no es necesario el estudio rutinario de la vía urinaria de estos pacientes.
Por su parte, otro estudio prospectivo (15) incluyó a 29 varones menores de 45 años consecutivos que presentaban un primer episodio de IU. Todos los pacientes fueron sometidos a una evaluación por imágenes, incluyendo ecografía y urografía endovenosa.
En aquéllos con hematuria macroscópica se realizó una cistoscopía. Además, se realizó un estudio de flujo alrededor del mes luego de la recuperación clínica, y los pacientes que tenían un flujo máximo menor a 15 mL/s fueron evaluados con estudio de presión de flujo. No se encontraron hallazgos de anomalías estructurales o funcionales significativas, hecho que sugiere que en este subgrupo de varones no sería necesario el estudio rutinario de la vía urinaria.
En razón de estos estudios es posible recomendar que, en ausencia de signos, síntomas o exámenes de laboratorio que lo justifiquen, la evaluación rutinaria con ecografía, pielografías o TAC no es necesaria, ya que raramente ofrece información que modifique la duración de tratamiento antibiótico o guíe a realizar intervenciones quirúrgicas. Las evaluaciones por imágenes deberían reservarse para aquellos pacientes que presentan fracaso terapéutico, recurrencia temprana sintomática o hematuria microscópica persistente, sugestiva de anomalías urológicas mayores.
En pacientes con vejiga neurogénica o IU recurrentes se recomienda realizar una cistoscopía y una ecografía, especialmente si se observaran alteraciones de la función renal. En estas situaciones se recomienda además evaluar el residuo posmiccional o efectuar estudios urodinámicos. La cistouretroscopía y las mediciones urodinámicas quedarán reservadas para quienes presentan historia de retención urinaria (14).
Existe en la actualidad un acuerdo respecto de que es primordial individualizar el marco clínico y es opinión de expertos que extensas evaluaciones urológicas infrecuentemente revelan anomalías importantes inesperadas (6). Por lo tanto, este Consenso Intersociedades recomienda que:
a – La indicación de evaluaciones en casos de IU en hombres debe centrarse en signos o síntomas o resultados de exámenes simples de laboratorio que lo justifiquen.
b – Las evaluaciones urológicas extensivas rutinarias raramente revelan anomalías importantes inesperadas.
c – La decisión de la realización y la selección de los exámenes complementarios deberá ser tomada por el médico tratante en forma individualizada, de acuerdo con su sospecha de la patología predisponente de IU en cada paciente en particular.
Puntos prácticos
*En ausencia de elementos clínicos o de laboratorio que lo justifiquen, la evaluación rutinaria del hombre con IU mediante ecografía, pielografía o TAC no es necesaria, ya que raramente conducen a cambios de conducta.
*Las evaluaciones por imágenes deberían reservarse para aquellos pacientes que presentan fracaso terapéutico, recurrencia temprana sintomática o hematuria microscópica persistente, sugestiva de anomalías urológicas mayores.
*La decisión de la realización y la selección de los exámenes complementarios deberá ser tomada por el médico tratante en forma individualizada, de acuerdo con su sospecha de la patología predisponente de IU en cada paciente en particular.
Infecciones Urinarias Recurrentes en Hombres
Cuando la IU recurre es necesario distinguir reinfección de recaída, según las siguientes definiciones:
Reinfección: nuevo episodio de IU producido por un nuevo organismo.
Recaída: IU producida por el mismo organismo que no ha sido erradicado.
La recaída frecuentemente se asocia a anomalías anatómicas o funcionales (p. ej. cálculos prostáticos, abscesos prostáticos, quiste renales infectados o prostatitis crónica).
Esta distinción suele ser dificultosa si el patógeno involucrado es E. coli, ya que la identificación de distintas cepas puede resultar más complicada para algunos laboratorios microbiológicos. En contraste, la infección por un patógeno menos frecuente, o un perfil de resistencia antibiótica infrecuente permite distinguir con mayor claridad entre una recaída y una reinfección.
En las recaídas debe sospecharse la presencia de una prostatitis crónica. En estos casos debe obtenerse una muestra luego de una expresión prostática, utilizando el procedimiento de las cuatro copas. El mismo consiste en lo siguiente: luego de un breve tratamiento con nitrofurantoína para eliminar bacteriurias, el paciente con vejiga llena recoge una muestra:
1- de chorro inicial y
2- de chorro medio.
3- El médico procede a efectuar un masaje prostático recogiendo la secreción obtenida y finalmente
4- Se recoge una muestra de la orina remanente.
En el caso de que la muestra prostática y/o la de orina remanente muestren un recuento de colonias diez veces mayor que la muestra inicial, el paciente presenta una prostatitis
bacteriana crónica. Es recomendable que este procedimiento sea realizado por urólogos, ya que en algunos estudios estos especialistas obtuvieron muestras más representativas.
Los criterios de prostatitis a partir del estudio de la secreción prostática obtenida mediante el masaje son: presencia de > 10-20 GB, leucocitos agrupados y/o cuerpos grasos ovales en el examen en fresco y/o un pH >7 (16,17). Una buena historia clínica y exámenes complementarios comunes pueden superar a este procedimiento, que resulta costoso, ya que consta de cuatro urocultivos, e incómodo para los pacientes. Por lo tanto, cuando una IU recae luego de un tratamiento apropiado, es posible asumir que el paciente tiene una prostatitis bacteriana y, en consecuencia, prescribir ATB adecuado frente a esta complicación.
Puntos prácticos
*Frente a un paciente de sexo masculino que reitera episodios de IU, debe procurar establecerse si se trata de una reinfección o de una recaída.
*Los resultados del urocultivo suelen orientar hacia alguna de las dos situaciones clínicas.
*En las recaídas debe considerarse la posibilidad de una prostatitis bacteriana crónica y obtenerse una muestra luego de una expresión prostática, mediante el procedimiento de las cuatro copas.
*Cuando una IU recae luego de un tratamiento apropiado, es posible asumir que el paciente tiene una prostatitis bacteriana y tratarla empíricamente.
Tratamiento de la Prostatitis Crónica
Es preciso destacar que la prostatitis crónica/síndrome de dolor pélvico crónico, que corresponde al 90%-95% de los casos de prostatitis, es una afección de etiología no completamente conocida, marcada por una combinación de dolor y síntomas urinarios y eyaculatorios. No existe aún un tratamiento uniformemente efectivo (18). De todos modos,en razón de que los uropatógenos están involucrados, aunque en un bajo porcentaje de los casos, el tratamiento ATB está recomendado.
Los tres mayores determinantes de la difusión y concentración de los agentes antimicrobianos en los fluidos prostáticos y tejidos son la liposolubilidad, la constante de disociación (pK) y la unión a proteínas.
El pH normal humano del fluido prostático es 6.5-6.7, y aumenta en las prostatitis crónicas a niveles de entre 7.0 y 8.3. Una gran concentración de agentes antimicrobianos en los fluidos prostáticos ocurre en presencia de un gradiente de pH a través de la membrana que separa el plasma del fluido prostático. La nitrofurantoína es un ácido poco soluble en lípidos (hidrofílico) con un valor de pK poco favorable para su difusión dentro de la próstata. La administración de dosis estándar de esta droga en hombres resulta en niveles < 1ug/mL en sangre, y los niveles esperados en los fluidos prostáticos suelen no ser terapéuticos.
Por el contrario, el análisis de las concentraciones de varias fluoroquinolonas en el fluido prostático y seminal y en tejido prostático muestra una clara ventaja de esta clase de fármacos no sólo respecto de sus concentraciones plasmáticas sino también en su penetración a estos sitios (19).
En la Tabla 1 se describen los regímenes recomendados para el tratamiento de la prostatitis crónica son (16,17):

Debe destacarse que una reciente revisión de estudios aleatorizados y controlados para el tratamiento de la prostatitis crónica/dolor pelviano crónico no encontró beneficios significativos universales y/o prolongados con los fármacos actualmente disponibles (20).
Además de los ATB, otros medicamentos, como alfa-bloqueantes, anti-andrógenos y antiinflamatorios han sido de ayuda para algunos pacientes (21). Por lo tanto, algunos expertos postulan que una terapia combinada, secuencial o simultánea, entre diferentes clases de drogas anti-microbianas, antiinflamatorias y anti-espasmódicas podría tener un mayor potencial para proveer una mejoría sintomática, especialmente en pacientes con síntomas de larga data (22).
En el paciente que persiste sintomático o presenta recurrencias de IU frecuentes luego del tratamiento de la prostatitis crónica, se recomienda efectuar otros estudios como ecografía, urografía excretora y evaluación del vaciado vesical (6). Nuevamente, este Consenso recomienda que la decisión de la realización y selección de los exámenes complementarios sea tomada por el médico tratante en función de la sospecha de patología predisponente de IU en cada paciente en particular.
Puntos prácticos
*La prostatitis crónica/síndrome de dolor pélvico crónico, que corresponde al 90%–95% de los casos de prostatitis, es una afección de etiología no completamente conocida, manifestada por una combinación de dolor y síntomas urinarios y eyaculatorios.
No existe aún un tratamiento uniformemente efectivo.
*Los regímenes ATB electivos recomendados para el tratamiento de la prostatitis crónica son ciprofloxacina, norfloxacina u ofloxacina.
*Los regímenes alternativos están constituidos por doxiciclina, minociclina o cotrimoxazol.
*Si a pesar de este tratamiento el paciente persiste sintomático o presenta recurrencias de IU frecuentes, se recomienda efectuar otros estudios como la ecografía, urografía excretora y evaluación del vaciado vesical.
Referencias Bibliográficas
1. Hooton TM, Stamm WE. Diagnosis and treatment of uncomplicated urinary tract infection. Infect Dis Clin North Am 1997;11:551-81.
2. Griebling T. Urologic Diseases in America Project: Trends in Resource use for Urinary Tract Infections in Men. J Urol 2005;173:1288-94.
3. Krieger JN, Ross SO, Simonsen JM. Urinary tract infections in healthy university men. J Urol 1993;149:1046-8.
4. Lipsky BA. Urinary tract infections in men. Epidemiology, pathophysiology, diagnosis and treatment. Ann Intern Med 1989;110:138-50.
5. Foxman B, Zhang L, Tallman P, Andree BC, Geiger AM, Koopman JS et al. Transmission of uropathogens between sex partners. J Infect Dis 1997;175:989-92.
6. Lipsky B, Schaberg D. Managing urinary uract infection. Hospital Practice 2000;35:53-59.
7. Spach DH, Stapleton AE, Stamm WE. Lack of circumcision increases the risk of urinary tract infection in Young men. JAMA 1992;267:679-81.
8. De Pinho AM, Lopes GS, Ramos-Filho CF, Santos O, De Oliveira MP, Halpern M et al. Urinary tract infection in men with AIDS. Genitourin Med 1994;70:30-4.
9. Lipsky BA, Ireton RC, Fihn SD, Hackett R, Berger RE. Diagnosis of bacteriuria in men: specimen collection and culture interpretation. J Infect Dis 1987;155:847-54.
10. Gleckman R, Esposito A, Crowley M, Natsios GA. Reliability of a single urine culture in establishing diagnosis of asymptomatic bacteriuria in adult males. J Clin Microbiol 1979;9:596-7.
11. Naber KG, Bergman B, Bishop MC, Bjerklund- Johansen TE, Botto H, Lobel B, and the Urinary Tract Infection (UTI) Working Group of the Health Care Office (HCO) of the European Association of Urology (EAU). EAU guidelines for the management of urinary and male genital tract infections. Urinary Tract Infection (UTI) Working Group of the Health Care Office (HCO) of the European Association of Urology (EAU). Eur Urol 2001;40:576-88.
12. Ulleryd P, Sandberg T. Ciprofloxacin for 2 or 4 weeks in the treatment of febrile urinary tract infection in men: a randomized trial with a 1 year follow-up. Scand J Infect
Dis 2003;35:34-9.
13. Pfau A. Urinary tract infections in healthy university men. J Urol 1994;151:705-6.
14. Ulleryd P, Zackrisson B, Aus G, Bergdahl S. Hugosson J, Sandberg T. Selective urological evaluation in men with febrile urinary tract infection. BJU International 2001;88:15-20.
15. Abarbanel J, Engelstein D, Lask D, Livne PM. Urinary tract infection in men younger than 45 years of age: is there a need for urologic investigation? Urology 2003;62:27-9.
17. Association of Genitourinary Medicine and the Medical Society for the Study of Venereal Diseases, Clinical Effectiveness Group. National guideline for the management of prostatitis. www.mssvd.org.uk. June 2001.
18. Habermacher GM, Chason JT, Schaeffer AJ. Prostatitis/chronic pelvic pain syndrome. Annu Rev Med 2006;57:195-206.
19. Wagenlehner FM, Weidner W, Sorgel F, Naber KG. The role of antibiotics in chronic bacterial prostatitis. Int J Antimicrob Agents 2005;26:1-7.
20. Dimitrakov JD, Kaplan SA, Kroenke K, Jackson JL, Freeman MR. Management of chronic prostatitis/chronic pelvic pain syndrome: an evidence-based approach. Urology 2006;67:881-8.
21. Potts JM. Therapeutic options for chronic prostatitis/chronic pelvic pain syndrome. Curr Urol Rep 2005;6:313-7.
22. Shoskes DA, Katz E. Multimodal therapy for chronic prostatitis/chronic pelvic pain syndrome. Curr Urol Rep 2005;6:296-9.






